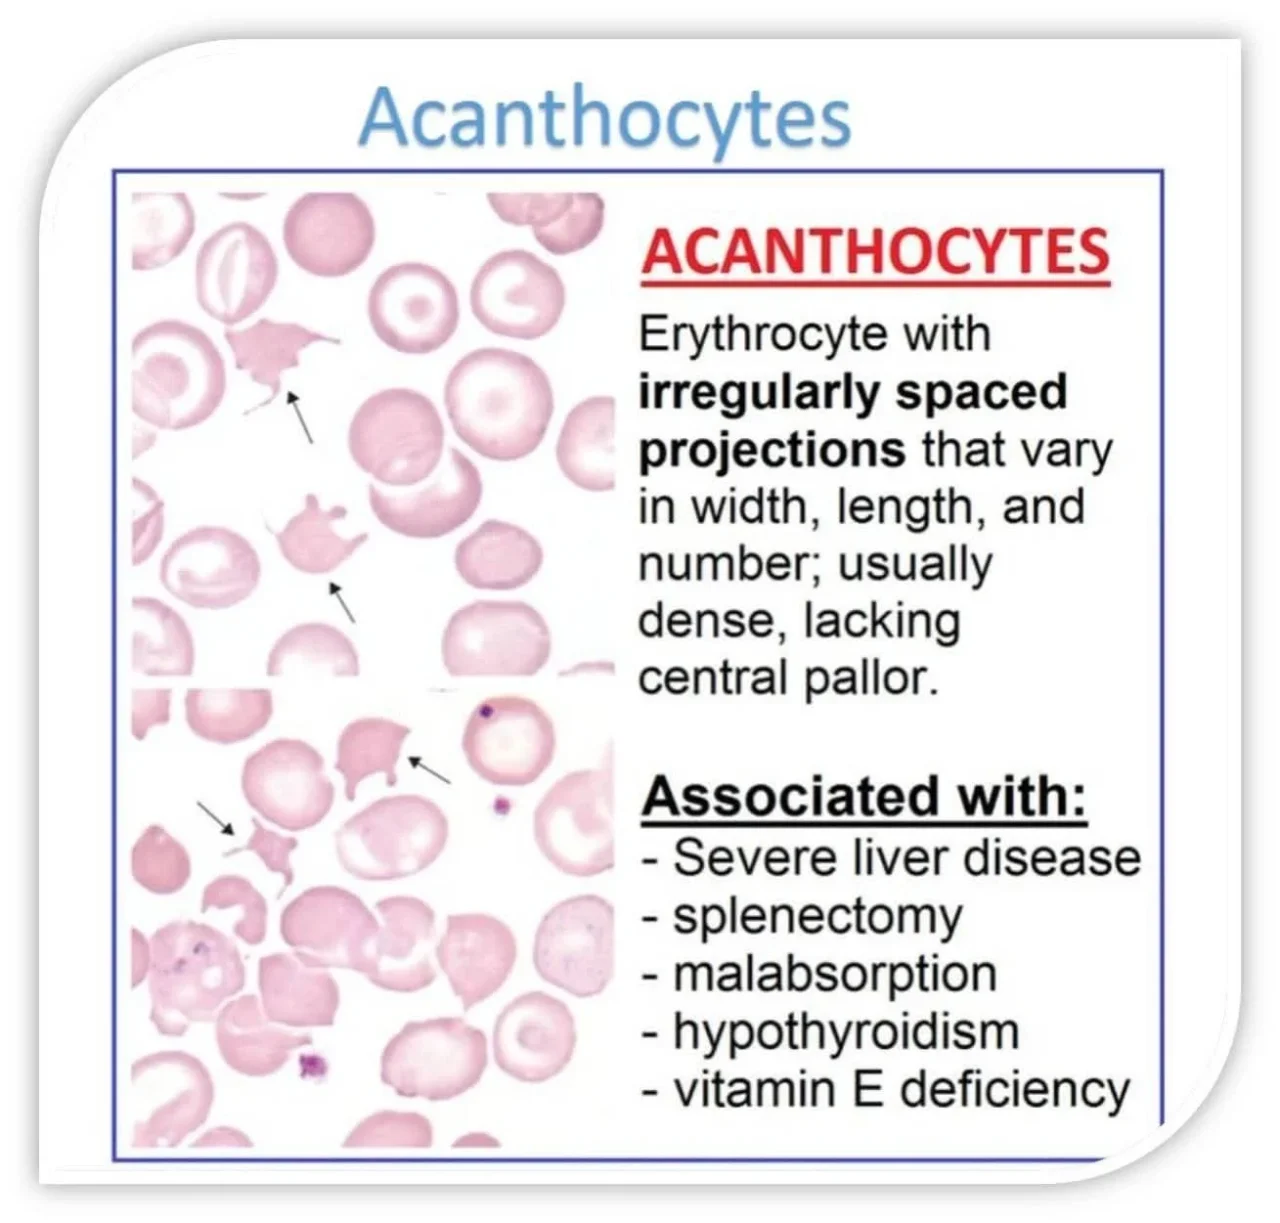
Omar Adwan: Understanding Clinical Significance and Diagnostic Implications of Acanthocytes 1 Omar Adwan: Understanding Clinical Significance and Diagnostic Implications of Acanthocytes

Omar Adwan: Understanding Clinical Significance and Diagnostic Implications of Acanthocytes
Omar Adwan, Medical Laboratory Technologist at Modawah Lab Center, shared a post on LinkedIn:
“Acanthocyte
Red Blood Cells with spiky projections of varying size, length, and distribution, giving it an irregular shape.
This differs from echinocyte, which has short, evenly spaced projections around the cell surface.
Conditions commonly associated with Acanthocytes
- Severe liver disease / Spur-cell anemia
Seen in advanced cirrhosis, where plasma lipid alterations lead to acanthocyte formation and severe hemolytic anemia.
- Abetalipoproteinemia (hereditary)
A genetic lipid disorder caused by defective MTP, leading to absence of apolipoprotein-B–containing lipoproteins, acanthocytosis, and fat-soluble vitamin deficiencies (e.g., vitamin E) with neurological manifestations.
- Neuroacanthocytosis syndromes
A group of neurological disorders associated with acanthocytosis, such as chorea- acanthocytosis (VPS13A) and McLeod syndrome (XK gene), often presenting with chorea, dystonia, neuropathy, etc.
- Others:
Post- splenectomy, malnutrition/anorexia, certain renal or metabolic disorders (clinical relevance varies).
Clinical significance
- Numerous acanthocytes – suggest severe disease, especially spur-cell anemia due to cirrhosis.
- Neurological symptoms – consider neuroacanthocytosis.
- Children with malabsorption – consider abetalipoproteinemia.”
See more in the gallery.
Stay updated with Hemostasis Today.
-
Mar 29, 2026, 16:01Ifeanyichukwu Ifechidere: Direct Oral Anticoagulants Broke Traditional Coag Testing
-
Mar 29, 2026, 16:00Amnah Alhanaee: Are We Over-Treating Portal Vein Thrombosis in Cirrhosis?
-
Mar 29, 2026, 15:59Huseyin Altaeh: Transient Ischemic Attack as a Warning Sign of an Impending Stroke
-
Mar 29, 2026, 12:00Christophe Vandenbriele: Bleeding on VA-ECMO Remains the Achilles’ Heel
-
Mar 29, 2026, 11:51Chokri Ben Lamine: 50 High Yield Pearls for Therapeutic Phlebotomy
-
Mar 29, 2026, 11:40Karim Ahmed: Why The Right DOAC Choice Still Depends on The Patient
-
Mar 29, 2026, 11:32Meryem El Kouchi: Pulmonary Embolism Is A Silent Life-Threatening Emergency
-
Mar 29, 2026, 11:23Bruno Pougault: How Understanding Vascular Mechanisms Could Transform the Future of VWD Management
-
Mar 29, 2026, 11:15Advancing Care for Women and Girls with Bleeding Disorders in Serbia – EHC